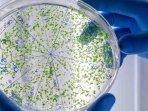

TOPIK
Apotek Online Lifepack
-
Lovastatin termasuk obat dalam golongan statin, yang berfungsi untuk membantu menyeimbangkan jumlah kolesterol di dalam darah.
-
Penjelasan mengenai asam malat atau L-malic acid dari Tim Lifepack, ditinjau oleh dr Fala Adinda.
-
L-Glutamine merupakan suplemen gizi yang menjadi nutrisi tambahan glutamine. Bagaimana dosis dan apa efek sampingnya?
-
Mengenal tentang obat Iodochlorohydroxyquinoline, mulsi dosis, efek samping hingga cara pemakaian.
-
Limfoma disebabkan oleh terjadinya mutasi DNA sel-sel limfosit sehingga muncul sel abnormal yang tumbuh dan berkembang secara tidak terkendali.
-
Kolin Bitartrat merupakan salah satu dari nutrisi penting bagi manusia. Terdapat pada makanan seperti hati, daging, ikan, kacang-kacangan.
-
Tuberkulosis atau TBC merupakan penyakit yang sampai saat ini masih menjadi masalah
kesehatan masyarakat di Indonesia.
-
Mengenal konsep telemedicine di Indonesia beserta kelebihan dan kekurangannya. Simak ulasan selengkapnya berikut ini.
-
Menurut Ketua APKS PGRI Kota Surabaya Didiek Budihardjo, dokter cilik memegang peranan penting dalam menyebarkan informasi kesehatan.
-
Selain skill, ada hal lain yang perlu dikembangkan. Bahkan saat seseorang masih di usia dini yakni, karakter
-
Mengenal autis alias Autism Spectrum Disorder (ASD). Berikut berbagai gejala yang timbul, faktor risiko hingga pengobatannya.
-
Banyak orang yang masih salah memahami HIV/AIDS dapat menular dengan bersalaman, padahal itu bukanlah cara penularan HIV yang benar.
-
Nutrisionist Lifepack dan Jovee, Kelvin Halim bagikan tip menjaga kesehatan mulut dan gigi. Salah satunya dengan menjaga pola makan.
-
Berikut ini adalah penjabaran mengenai pengertian virus dan bakteri serta cara pengobatan infeksi yang disebabkan oleh virus dan bakteri.
-
Awas! Ternyata hipertensi bisa sebabkan stroke lho, berikut ini adalah cara mencegah tekanan darah tinggi.
-
Inilah vitamin buat daya tahan tubuh yang bagus dan aman, apa saja? Simak penjelasannya di sini! Ternyata tidak semua vitamin.
-
Inilah seluk beluk HIV dan AIDS, mulai dari definisi, gejala-gejala yang timbul, hingga pengobatan yang bisa dilakukan.
-
Mengenal Staphylococcus aureus, bakteri berbahaya yang perlu dihindari, sebabkan beberapa penyakit.
-
Berikut tanda-tanda menopause pada wanita serta cara mengelola gejala yang dirangkum tim Lifepack.
-
Terdapat berbagai macam hal yang dapat menyebabkan seseorang mengalami muntah darah.
-
Apotek digital Lifepack & Jovee, aplikasi rekomendasi suplemen dan multivitamin secara personal kembali mengadakan kegiatan Dokter Cilik.
-
Apoteker Lifepack dan Jovee, Lydia Vanessa sarankan melakukan konsultasi dengan dokter jika merasakan sakit. Gratis di aplikasi telemedik Lifepack.
-
Apoteker Lifepack dan Jovee, Lydia Vanessa bagikan standart obat-obatan yang perlu ada di rumah dalam Dokter Cilik Batch 2020.
-
Penyakit yang disebabkan oleh virus bisa sangat beragam, yakni mulai dari yang ringan bahkan ada pula yang tergolong berat.
-
Tim Lifepack ditinjau dr Irma Lidia merangkum gejala penyakit yang disebabkan virus dan 10 jenis penyakit yang disebabkan oleh virus.
-
Tim Lifepack ditinjau dr Irma Lidia merangkum beberapa penyebab sakit tenggorokan. 4 peyakit ini bisa jadi penyebab.
-
Apa aja bahaya osteoporosis? Lalu apa saja gejala yang perlu Anda ketahui? Simak selengkapnya pada ulasan yang telah Tim Lifepack rangkum berikut ini.
-
Layanan telemedicine menjadi di opsi utama pelayanan kesehatan di tengah pandemi virus Corona. Kenapa? simak penjelasan Tim Lifepack.
-
Lifepack, apotek digital pertama di Indonesia sebagai penyedia layanan obat terlengkap, telah resmi membuka layanannya di kota Surabaya.
-
Menopause merupakan masa ketika periode menstruasi seorang wanita berhenti secara permanen.